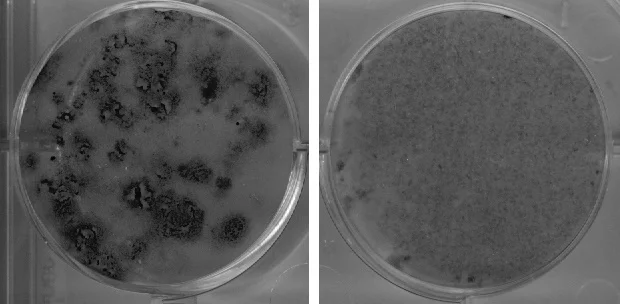
Dafna

Zarouhie Abdalian
Learn more about Zarouhie's work.

We come to you this week from San Francisco's Exploratorium, where we met with artist-in-residence Zarouhie Abdalian. For her assignment, she wants you to focus on boundaries and the relationships between the spaces they separate.
instructions
1. Find two spaces that share a boundary
2. Do something to highlight or alter the relationship between those two spaces
3. Document it in some way and upload using #theartassignment
4. Fame and glory (your work might be in a future episode)
featured responses
Featured